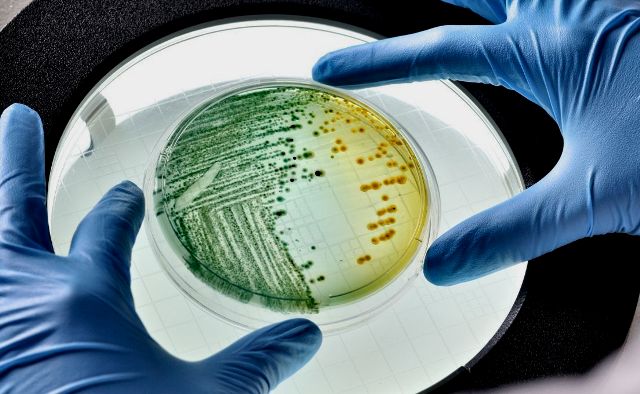
7241

Investigadors japonesos desenvolupen una teràpia gènica pionera per tractar la pèrdua auditiva
La pèrdua auditiva congènita es deu, en gran mesura, a mutacions en el gen GJB2, que codifica la proteïna connexina 26 (CX26), essencial per a la formació d’unions gap entre cèl·lules de l’oïda interna. Aquestes estructures permeten la comunicació intercel·lular i resulten vitals per a l’audició. Mentre que les mutacions recessives de GJB2 poden tractar-se mitjançant la substitució del gen, les mutacions dominant-negatives, com la R75W, requereixen enfocaments més complexos, ja que la proteïna defectuosa interfereix directament amb la funció de la proteïna normal.
Per superar aquest desafiament, l’equip dirigit pel Dr. Kazusaku Kamiya i el Dr. Takao Ukaji, de la Facultat de Medicina de la Universitat de Juntendo, juntament amb el Dr. Osamu Nureki, de la Universitat de Tòquio, va desenvolupar un sistema d’edició genòmica d’alta precisió utilitzant un vector AAV (virus adenoassociat) modificat. Aquest vector, denominat AAV-Sia6e, va ser dissenyat per transportar una versió miniaturitzada d’una eina d’edició de bases, capaç de corregir la mutació R75W directament en l’ADN de les cèl·lules de l’oïda interna…[…] consalud.es
Descobriu-ne més des de LESCRONIQUES.COM
Subscribe to get the latest posts sent to your email.















